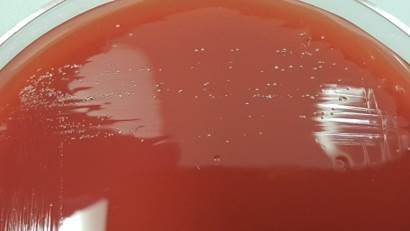
actscha2

Case History
A 56 year old man with a history of hypertension, asthma and COPD, bladder stones, congenital bladder abnormality, and bladder exstrophy presented to the ED with fatigue, generalized weakness, poor appetite, fever, and nausea. He had intermittent right flank pain and generalized abdominal pain. The patient also reported he had passed bladder stones in the past year.
In the ED he had an elevated peripheral white blood cell count of 12.9 x103/μl with a differential of 81% neutrophils, 11% lymphocytes, and 6% monocytes. His creatinine was elevated at 5.4 mg/dl. CT imaging of the urogenital tract showed hydronephrosis with evidence of infection.
Blood and urine specimens were sent for culture. The urine culture grew 10-50,000 cfu/ml Aerococcus urinae. After 30 hours of incubation, the anaerobic blood culture was positive for small, coccoid-looking gram positive rods (Image 1). The following bacteria grew on solid media under anaerobic conditions after 48 hours of incubation (Image 2).

Discussion
The organism growing in the blood culture was identified as Actinotignum schaalii. A. schaalii is a facultative aerobe that prefers enriched media and grows best in anaerobic or 5% CO2 environments. It is a non-hemolytic, non-motile, and non-spore forming Gram-positive rod. A. schaalii is negative for catalase, oxidase, CAMP factor, and nitrate reduction, but is hippurate positive. It is also negative for lactose, mannitol, raffinose, sorbitol, and trehalose acid production.
Actinotignum schaalii was formerly named Actinobaculum schaalii. The Actinotignum genus now consists of A. urinale, A. sanguinis, and A. schaalii. A. schaalii is part of urogenital microbiota in healthy adults and can cause urinary tract infections, especially as it thrives in the humid atmosphere of diapered children or elderly adults. Isolation of this organism is associated with urinary incontinence, bladder cancer, catherization, neurogenic bladder, renal failure, prostate cancer, and chronic renal failure. The presence of A. schaalii in the urogenital tract can progress to bacteremia and rarely it can also cause groin abscesses.
Actinotignum schaalii is an under recognized uropathogen due to its fastidious nature—it is slowly growing and prefers enriched media grown under anaerobic conditions. None of these conditions are met as part of a routine urine culture as urine cultures are often finaled in < 48 hours, they may not use enriched media, and they are incubated under aerobic rather than anaerobic conditions. Because of these factors, A. schaalii rarely grows in urine culture despite it being a known colonizer of the urogenital tract and occasional uropathogen. Instead it is most commonly recovered from blood cultures as a result of urosepsis. When colonies do grow from blood culture, they are very difficult to identify by biochemical methods. A. schaalii is often misidentified by biochemical panels as Arcanobacterium spp. or Gardnerella vaginalis (API Coryne system, bioMerieux), Actinomyces meyeri (Rapid ID32A system, bioMerieux), or Actinomyces israelii (Rapid ANA II system, Remel). In our lab Bruker Biotyper MALDI-TOF MS was able to identify A. schaalii with high confidence. Based on the most current literature, Vitek MS misidentifies A. schaalii as G. vaginalis or A. meyeri. This data is from 2015, so it’s possible the Vitek MS spectra database has been updated and now identifies A. schaalii.
A. schaalii is routinely susceptible to all β-lactams but requires an extended duration of antimicrobial treatment compared to other uropathogens. It is resistant to trimethoprim/sulfamethoxazole and quinolones, both of which are commonly prescribed for urinary tract infection. Therefore, patients with A. schaalii are at risk for recurrent urinary tract infections due to inappropriate or inadequate antibiotic treatment.
Our patient was prescribed ciprofloxacin for presumed urinary tract infection prior to his bacteremia. He was switched to ceftriaxone upon hospital admission. His bacteremia was cleared and the patient was discharged 5 days later on an oral β-lactam antibiotic.
References
- Lotte, R., L. Lotte, and R. Ruimy. “Actinotignum schaalii (formerly Actinobaculum schaalii): a newly recognized pathogen—review of the literature.” Clinical Microbiology and Infection1 (2016): 28-36. Le
- Le Brun, Cécile, et al. “Urinary tract infection caused by Actinobaculum schaalii: a urosepsis pathogen that should not be underestimated.” JMM Case Reports2 (2015).
- Manual of Clinical Microbiology, 11th edition

-Erin McElvania, PhD, D(ABMM), is the Director of Clinical Microbiology NorthShore University Health System in Evanston, Illinois.